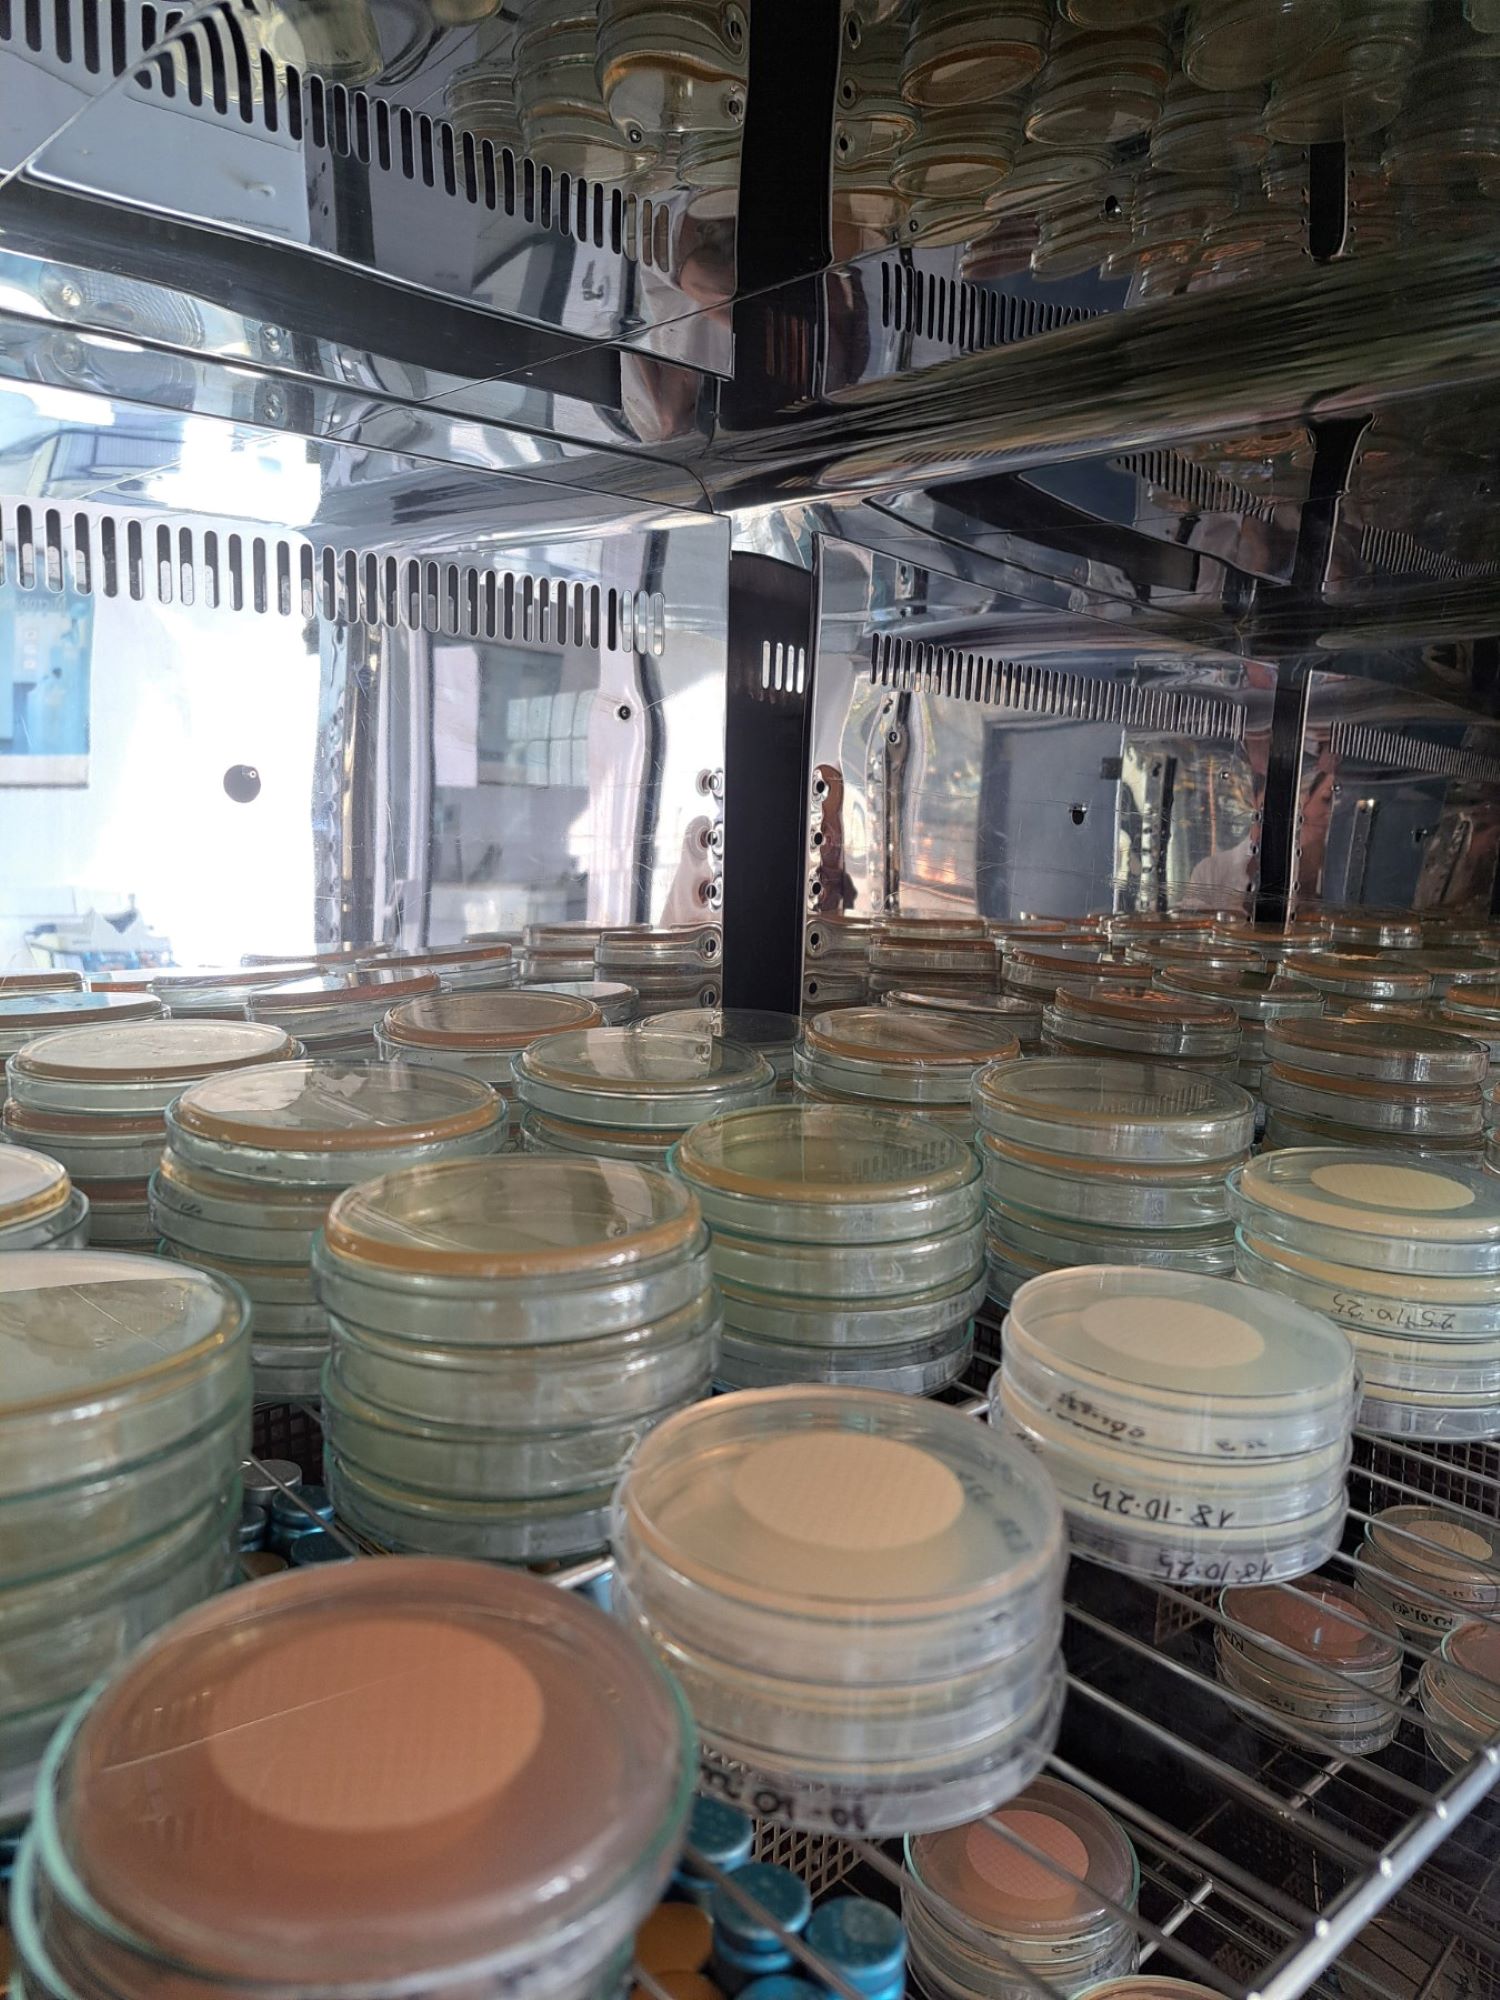

Дневни мониторинг активности за испитување на квалитетот и безбедноста на водата за пиење
Во текот на ден 09.03.2026 од страна на Сектор Санитарна контрола при ЈП Водовод и канализација Скопје, се земени:
42 примероци од водоводната мрежа на град Скопје;
Мониторингот се работи согласно Правилник за барања за безбедност и квалитет на водата за пиење бр.183/2018 (Прилог 2, Дел Б). Примероците се земени согласно метода MKC ISO 5667-5 Земање на примероци – Дел 5: Упатство за земање на примероци вода за пиење од пречистителни станици и водоводни дистрибутивни системи. На сите примероци ќе им биде изработена физичко-хемиска и микробиолошка анализа согласно Правилник за барања за безбедност и квалитет на водата за пиење бр.183/2018 (Прилог 4,Основен преглед-А) во акредитираните лаборатории при Сектор Санитарна контрола согласно ISO 17025:2018.
Согласно добиените резултати од испитувањата, сите примероци од водоснабдителниот систем на град Скопје ОДГОВАРААТ на Правилникот за барања за безбедност и квалитет на водата за пиење(Службен весник на РМ, бр.183/18).